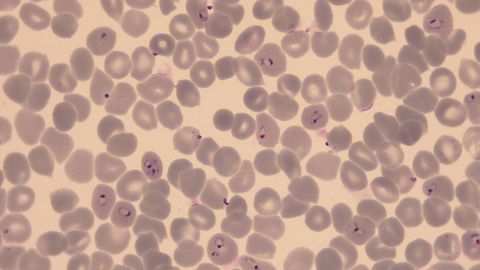

Excellence in Science - Research at Swiss TPH
Swiss TPH excels in scientific research in a wide range of fields, including parasitology, infection biology, epidemiology, public health, and health systems and economics. Our aim is to advance knowledge on disease and health systems while developing innovative tools and interventions.
We conduct research at all stages stage, from basic to translational and implementation science, bridging the gap between laboratory studies and real-world applications. Our focus spans infectious and non-communicable diseases, focusing on molecules, genes, cells, individuals, communities and populations. Using cutting-edge digital methods and interdisciplinary approaches, we integrate diverse methodologies across diseases and social-ecological systems.
Swiss TPH operates along a value chain from innovation to validation and application. New diagnostics, drugs, vaccines and tools are rigorously tested in real-world settings and integrated into health systems and policies.
Long-term, trusted partnerships are central to our success. Our strengths in basic science, combined with our expertise in personalised, public and global health, enable us to advance the understanding of diseases and health systems and drive innovation to improve global health.
Research News
All NewsSSPH+ Journals Editorial Office
Swiss TPH is home to the editorial office of two public health journals: The International Journal of Public Health and Public Health Reviews. These two independent society journals are owned and published by the non-profit Swiss School of Public Health (SSPH+) using the systems and services of Frontiers. Christopher Woodrow is the managing editor of both journals at Swiss TPH. The journals are published Gold Open Access and offer APC waiver schemes for researchers from low and middle income countries and SSPH+ affiliates. More information